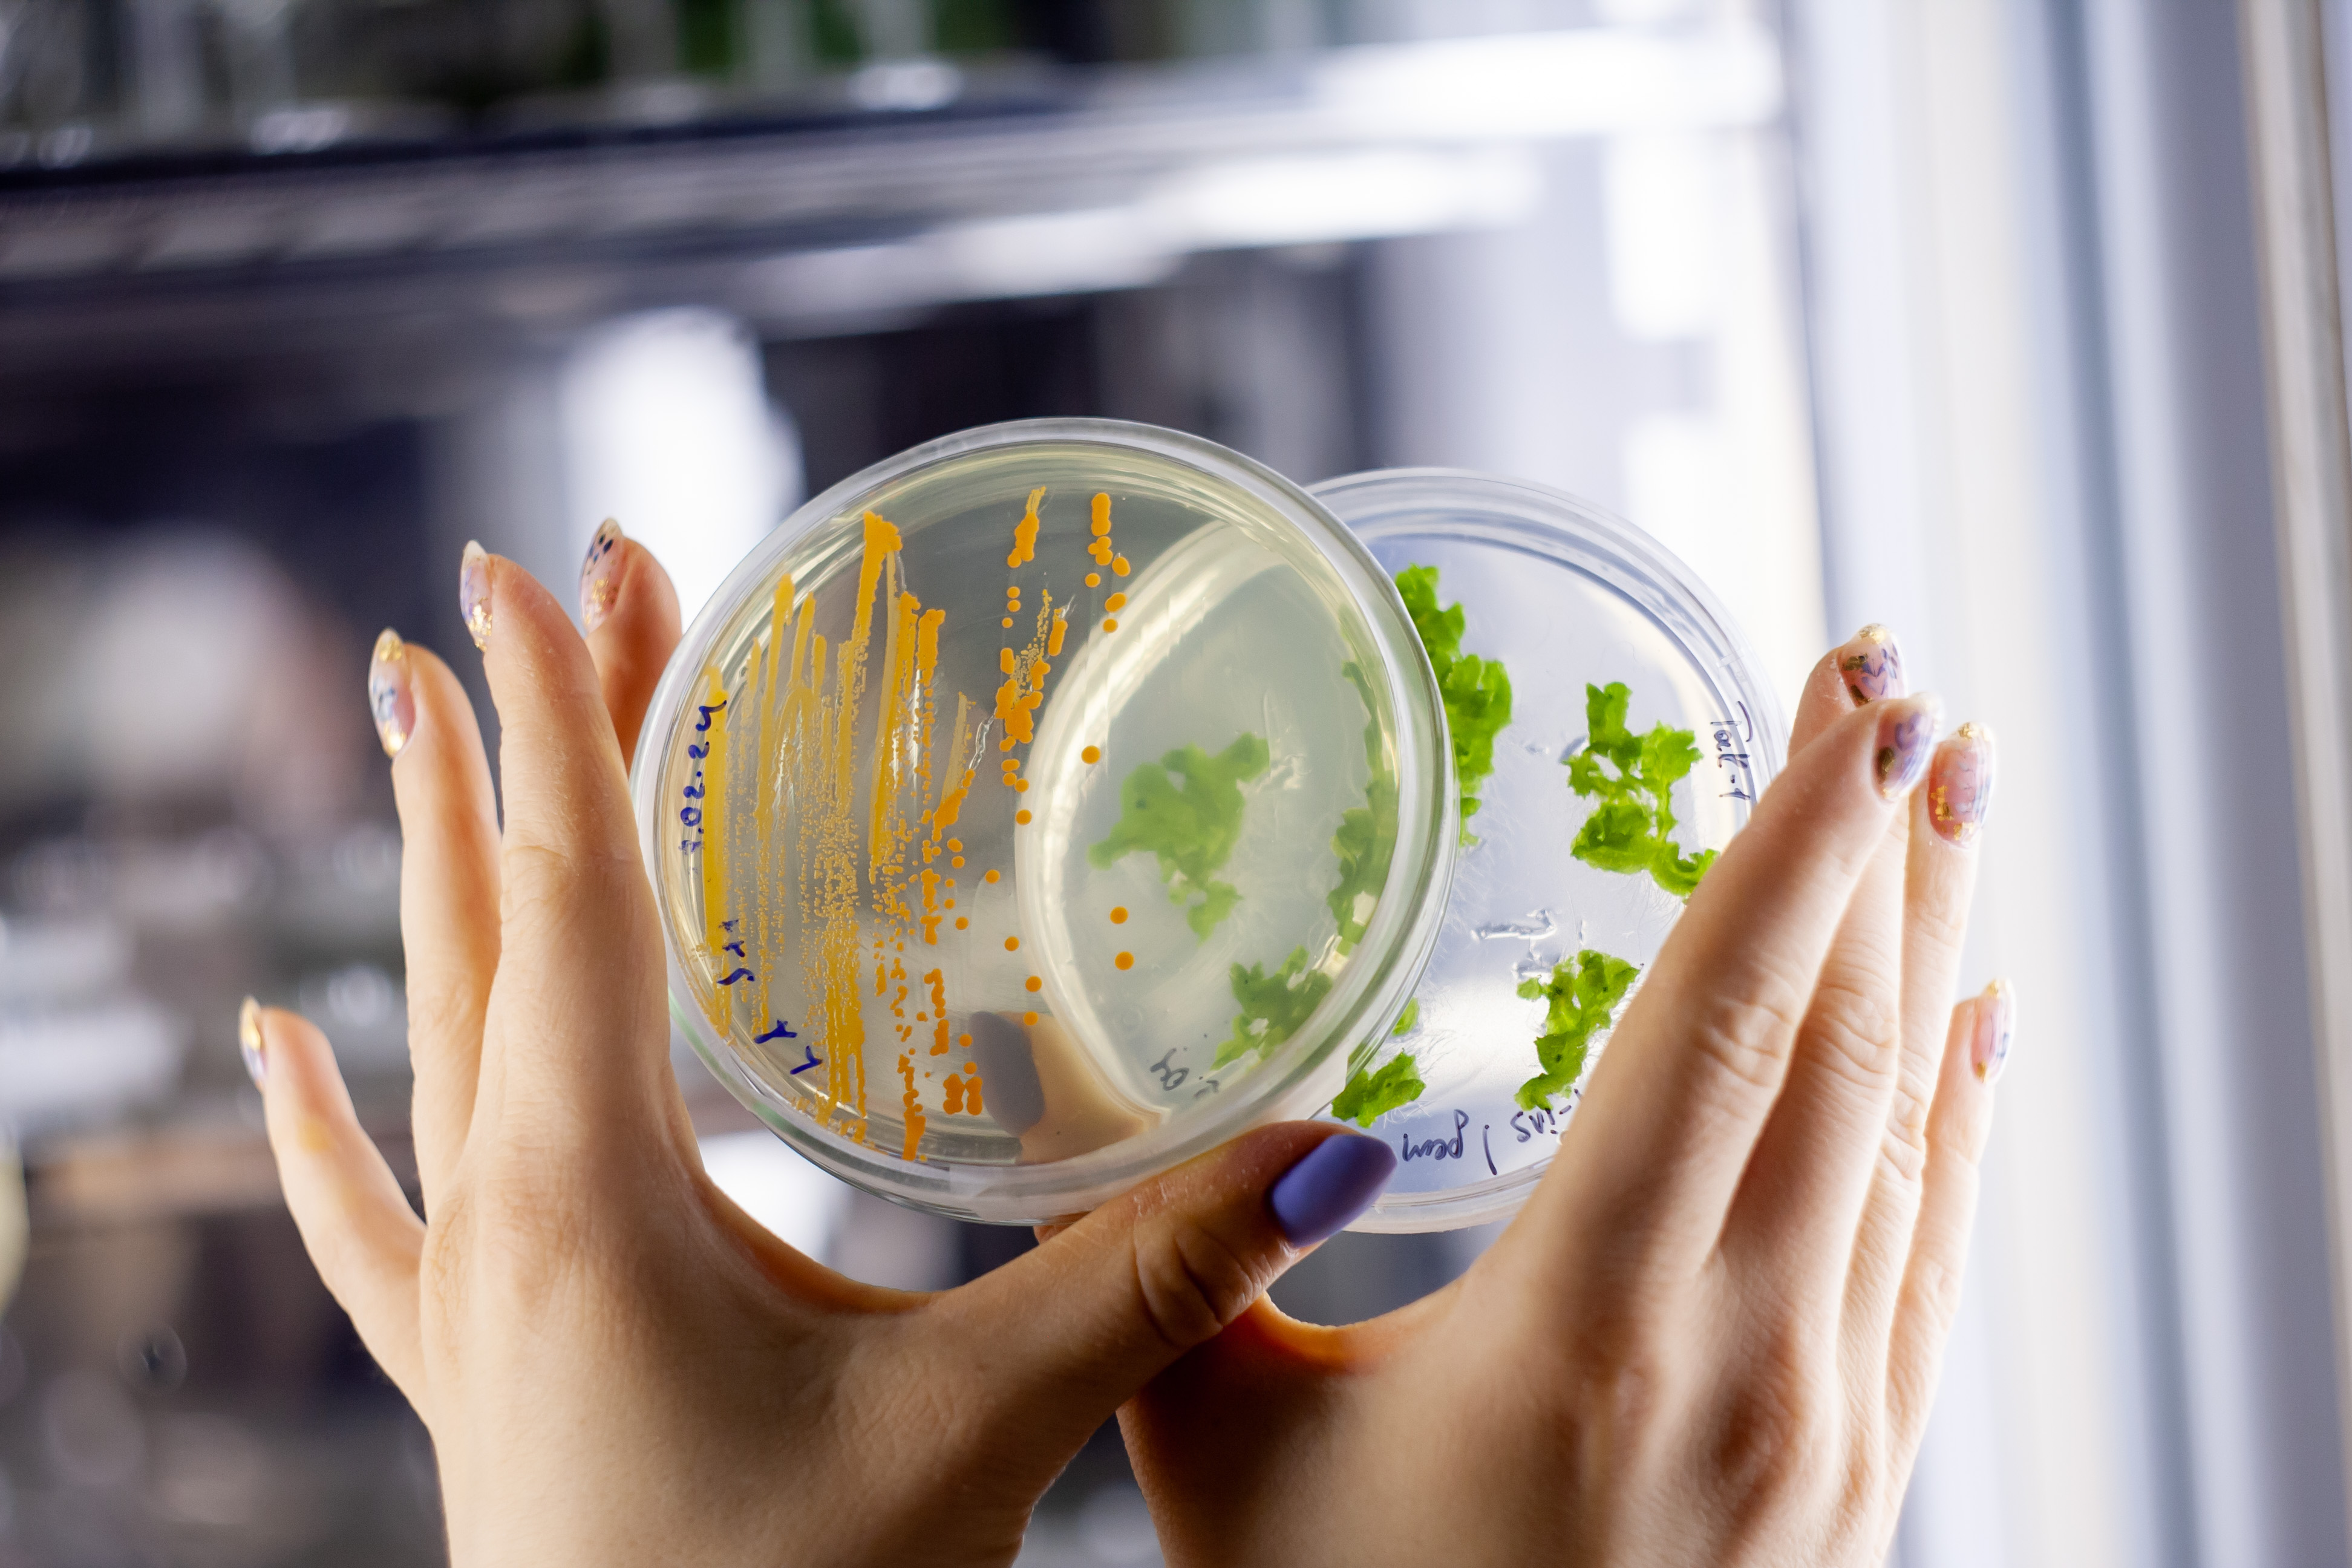
Студентка кафедры микробиологии и лаборант НИЛ 'Агробиоинженерии' Татьяна Ивойлова заняла I призовое место в финале IX Всероссийского молодежного научного форума 'Наука будущего - наука молодых' в г. Самара Студентка кафедры микробиологии и лаборант НИЛ 'Агробиоинженерии' Татьяна Ивойлова заняла I призовое место в финале IX Всероссийского молодежного научного форума 'Наука будущего - наука молодых' в г. Самара

Осенью 2024 года на базе Самарского национального исследовательского университета имени академика С.П. Королева прошел финал IX Всероссийского молодежного научного форума «Наука будущего - наука молодых». Это значимое событие собрало молодых ученых и студентов со всей страны, чтобы продемонстрировать свои научные исследования и достижения.
Среди студентов в секции «Агро-, био- и продовольственные технологии» призовое I место заняла студентка кафедры микробиологии и лаборант НИЛ «Агробиоинженерии» Татьяна Ивойлова, успешно представившая свою научную работу на тему «Эндолитный штамм Nocardia mangyaensis NH1, обладающий ростостимулирующей активностью».
Работа Татьяны является особенно актуальной в свете современных тенденций к биологизации земледелия. Эндолитные бактерии могут быть использованы как биопрепараты и биоудобрения, а также служить источниками новых соединений, что открывает новые горизонты в агрономии. Успехи студентов и молодых ученых, таких как Ивойлова Т.М., подчеркивают важность исследований в этой области и делают вклад в устойчивое развитие сельского хозяйства.
Казанский федеральный университет гордится достижениями своих студентов и поддерживает инициативы по развитию научных исследований в области агробиоинженерии и микробиологии. Мы надеемся, что работы, подобные исследованию Ивойловой Т.М., станут основой для будущих открытий и приведут к практическим решениям в области сельского хозяйства.